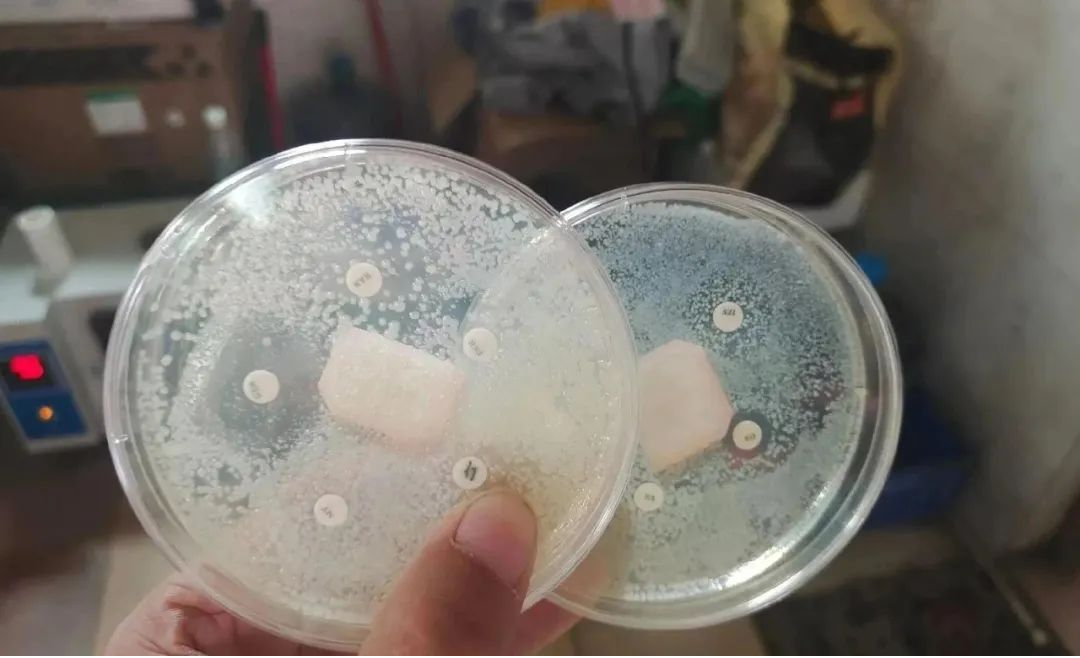

恩诺沙星,又名乙基环丙氟哌酸或乙基环丙沙星,该药由德国拜尔公司研制,1987年在新西兰首次上市,我国于1993年成功研制生产,为动物专用第三代氟喹诺酮类药物,主要抑制DNA旋转酶,使细菌DNA不能正常复制,从而起到抑制细菌的作用,对革兰氏阳性菌和革兰氏阴性菌均有效,尤其是对革兰氏阴性菌作用更强。恩诺沙星属于第三代喹诺酮类抗生素,是水产行业中应用最广泛的抗生素,主要用于:嗜水气单胞菌引起的出血和腹水症状。它是一种广谱高效的抗生素,可以治疗水生动物如鱼类,虾蟹等出血性败血症,烂鳃打印肠炎体表溃疡等病症。

一、恩诺沙星药效学研究
任何一种药物的合理给药方案都应该是建立在药动学研究和药效学研究的基础上。恩诺沙星对水产养殖动物上的大多数病原菌都有抗菌活性,如张雅斌等用恩诺沙星对5种淡水养殖鱼类常见病、多发性致病菌进行抑菌试验,获得了恩诺沙星对细菌出血性败血病、打印病、赤皮病、烂鳃病、肠炎病致病菌的最小抑菌浓度(MIC)分别为0.02、0.04、0.63、0.31、0.04毫克/升;杨雨辉等测定了恩诺沙星对嗜水气单胞菌的MIC与MBC值为0.0125毫克/升和0.05毫克/升;樊海平等测定盐酸恩诺沙星对嗜水气单胞菌和温和气单胞菌的MIC与MBC值,均为0.0488毫克/升,且作用效果优于盐酸环丙沙星。
国外的研究结果也表明,恩诺沙星对水产动物的病原菌有良好的抑杀能力。Roque等从墨西哥西北部养殖的南美白对虾群体分离了144株弧菌,并进行了15种抗生素包括恩诺沙星、氟甲砜霉素、土霉素等的敏感性实验。结果表明,所分离的144株弧菌中只有3株对恩诺沙星不敏感。恩诺沙星对余下141株菌的平均最小抑菌浓度MIC为0.45毫克/升。Bowser等通过体外试验表明,恩诺沙星对鱼类大多数病原菌的MIC约为0.16毫克/升,对最敏感的耶尔森氏菌的MIC约为0.005毫克/升,对不敏感的链球菌的MIC为0.25~0.45毫克/升。
根据恩诺沙星的体外抑菌试验,恩诺沙星对敏感的病原微生物的最小抑菌浓度小于0.1毫克/升,如气单胞菌等,但对弧菌、链球菌等病原微生物的最小抑菌浓度约为0.2~0.63毫克/升。
二、如何确定恩诺沙星使用剂量
通过药敏试验确定使用恩诺沙星后,紧接着就是确定用药剂量。多数情况药物剂量和效果是成正相关的,如果剂量不够不仅没有效果,还会因为长期低剂量用药,导致鱼体质变差等副作用。
现在内服抗菌药面临一个争议:到底是按存塘鱼的重量,还是按当前鱼的吃料量来添加抗菌药物?如果按存塘鱼的重量,来换算抗菌药的使用量,因很大一部分发病鱼都处于不吃料阶段,只有部分鱼上料台吃料,这时如果按存塘量来换算抗菌药使用量,相当于在超剂量给吃料的鱼内服药物,可能出现内服后吐料或吃一会就散开的现象,严重的会损伤体质。
如果是按投喂量,来换算内服抗菌药物的量,发病期间很多养殖户都有减料或控料习惯,按投喂量换算,经常造成内服抗菌药的剂量不够,最后处理效果不理想,耽误治疗进度。
所以在选定抗菌药后,建议当天适当抛网,估算池塘发病鱼的比例、吃料鱼和不吃料鱼的比例,综合考虑再制定用药剂量。也可以在当天和投喂抗菌药期间,做好调水抗应激、加开增氧机,促进病情较轻的鱼上台吃料,改善整体的吃料情况,提升内服抗菌药的效果。

三、严格执行恩诺沙星休药期
恩诺沙星的主要代谢产物是环丙沙星,因此恩诺沙星休药期的制定必须考虑环丙沙星的残留,通过模拟养殖实际,在(27±2)℃条件下,每天以剂量为50微克/克(鱼体重)的恩诺沙星分别给吉富罗非鱼、中国对虾投喂药饵,周期为7天,组织中恩诺沙星和环丙沙星残留要达到标准,在罗非鱼休药期为22天(550~638度日),中国对虾为12天(300~348度日),在26~28℃及18~22℃水温下,以50毫克/千克环丙沙星的剂量对鳗鲡进行灌胃给药,结果在26~28℃水温下用药的鳗鲡,其上市前环丙沙星的停药期应不少于9天(234~252度日),而在18~22℃水温下用药的鳗鲡,其停药期应不少于21天(378~462度日)。但按10~20毫克/千克恩诺沙星在鲤鱼、中国对虾、青鱼等水产动物体内的药代动力学参数计算,在25~28℃水温条件下,恩诺沙星和环丙沙星在体内残留时间约为7~9天(175~252度日)。因此,我们建议恩诺沙星使用后的休药期为:鱼类为400度日,虾蟹等甲壳动物为300度日。

四、恩诺沙星使用注意事项
1.禁止和含阳离子药物,如制酸药,氢氧化铝,或益生菌添加剂,同时内服,否则会影响对药物的吸收,禁忌与利福平等有拮抗作用的药物配合使用。
2.使用的时候要均匀拌饵,然后投喂,还要避免与制酸类同时使用,使用过的包装物需要集中在一起,然后进行销毁。
3.肉食动物和肾功能不全的动物要小心使用,有严重肾病或者肝病的动物需要调节用量后使用,避免体内药物蓄积,造成危害。
4.恩诺沙星不能用于预防使用,只能用于治疗。如果将安诺沙星用于预防,只会培养病菌对恩诺沙星的抗药性,会严重影响下一次恩诺沙星的治疗效果。其次,恩诺沙星用于治疗时一定要精准计算药物剂量,最好按鱼类体重来核算。恩诺沙星可采用饱和剂量法、要干就一次干足量干彻底,不留隐患。当池塘鱼类超过五万斤或更多时,适当改变投喂药物饲料的方式,前半程投喂正常饲料,后半程投喂拌了药物的饲料,让更多药物饲料被体弱多病的吃掉。
5.如果使用恩诺沙星外泼,严禁与戊二醛、甲醛、聚维酮碘、乳酸菌前后使用,会导致毒性增强,疗效降低,恩诺沙星严禁与含钙镁铝等金属离子的电解多维一起内服,熬合离子除外,金属离子会沉淀,导致恩诺沙星失效,恩诺沙星严禁与氟苯尼考和多西环素一起内服,疗效会下降。
转载申明
来源:华中渔业研究社

技术推广
盐城市农业农村局